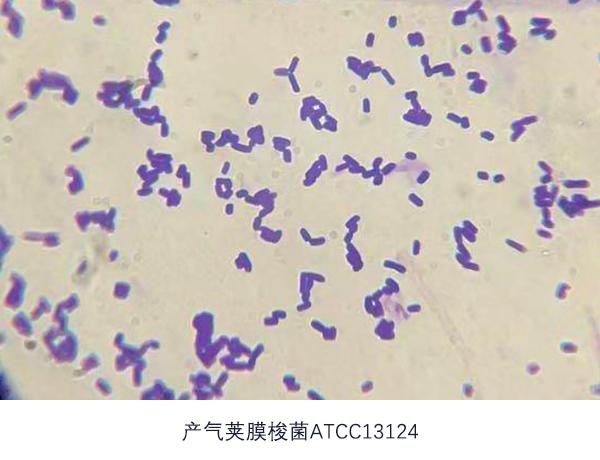
Image

常见细菌的革兰氏染色观察
发布时间:2024-09-16
1884年,丹麦医生汉斯·克里斯蒂安·革兰发明了一种划时代的细菌鉴别方法——革兰氏染色法。这一方法通过利用细菌细胞壁的生物化学性质差异,将细菌分为革兰氏阳性(G+)和革兰氏阴性(G-)两大类,在细菌学研究和临床诊断中发挥了重要作用。
革兰氏染色法的基本原理是利用细菌细胞壁的结构差异。 革兰氏阳性菌的细胞壁较厚,主要由肽聚糖组成,而革兰氏阴性菌的细胞壁较薄,含有更多的脂质。在染色过程中,细菌首先用碱性染料结晶紫染色,然后用碘液媒染。这一步骤会在细菌细胞壁内形成不溶于水的结晶紫与碘的复合物。随后,用酒精进行脱色。革兰氏阳性菌由于其细胞壁结构致密,能够保留复合物而呈现紫色;革兰氏阴性菌的细胞壁结构较松散,复合物被酒精溶解,最终在复染后呈现红色。
这一染色方法的操作步骤相对简单,主要包括涂片固定、初染、媒染、脱色和复染五个步骤。 然而,看似简单的操作却蕴含着深刻的科学原理。革兰氏染色法不仅能够帮助研究人员区分不同类型的细菌,还为临床医生提供了快速诊断和选择抗生素的重要依据。
在临床实践中,革兰氏染色法的应用非常广泛。 它可以帮助医生快速判断感染是由革兰氏阳性菌还是革兰氏阴性菌引起的,从而指导抗生素的选择。例如,革兰氏阳性菌通常对青霉素类抗生素敏感,而革兰氏阴性菌则对氨基糖苷类抗生素敏感。这种方法可以在短短5分钟内提供初步结果,为及时治疗提供重要信息。
然而,革兰氏染色法也存在一定的局限性。 首先,并非所有细菌都能通过这一方法准确分类,例如分歧杆菌就需要使用抗酸染色法进行鉴别。其次,染色结果可能会受到多种因素的影响,包括细菌的培养时间、培养基成分、染色液的浓度和质量等。例如,如果细菌培养时间过长,可能会导致染色性发生变化,影响结果的准确性。
此外,操作过程中的细节也会影响最终结果。例如,涂片过厚可能导致革兰氏阴性菌被误认为革兰氏阳性菌;脱色时间过长或过短都可能影响结果的准确性。因此,在进行革兰氏染色时,需要严格控制操作条件,确保结果的可靠性。
尽管存在这些局限性,革兰氏染色法仍然是微生物学和临床诊断中不可或缺的重要工具。它不仅为细菌分类提供了基础,也为抗生素的选择和使用提供了重要指导。随着医学技术的不断进步,革兰氏染色法可能会面临新的挑战,但它在微生物学和医学诊断中的重要地位是不可否认的。